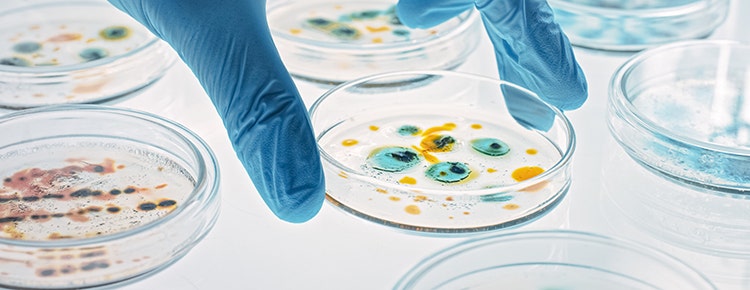

Jean-Pierre
MoULOUDJ
My name is Jean-Pierre Mouloudj, and I am currently a pre-med student aspiring to research specific science-related subjects outside of my school’s curriculum that are out of interest. I have had many projects in the past, including a nonprofit that I started with my mother called Giving Fruits, and experiments that explored the preliminary steps to comprehend the functionality of CRISPR.

Contents:
Contact Information:
For any inqueries, please refer to my email:
jeanpierre.mouloudj@gmail.com